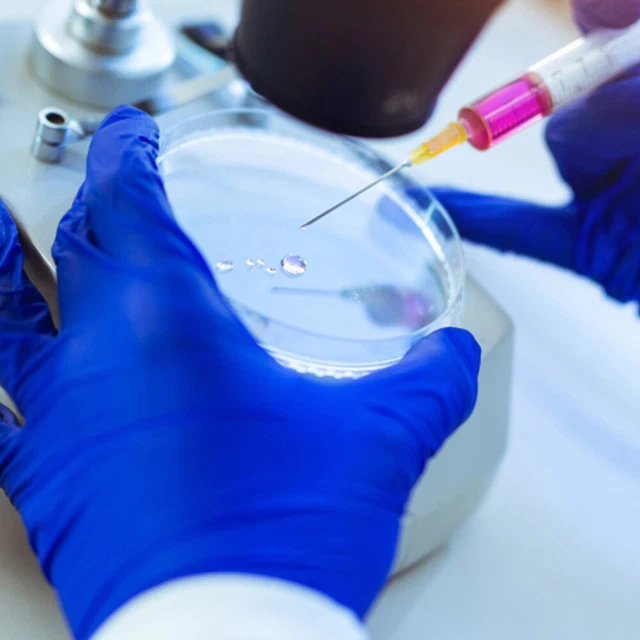
10 Piastre Di Petri Con Agar - Diametro 7 Cm, Per Esperimenti Scientifici E Educativi, Pre-Colate - Foto 6

10 Piastre Di Petri Con Agar - Diametro 7 Cm, Per Esperimenti Scientifici E Educativi, Pre-Colate
Disponibile
Disponibile
€ 16
AGGIUNGI AL CARRELLO
Consegna
- Corriere espressoda lunedì 23 febbraioGRATIS
Venduto e spedito da ePRICE

Altri 23 venditori a partire da € 16
- Informazioni legali
- Ne hai uno da vendere?
- 424894
- 95998887549
Pensati per Te
Prodotti simili
Descrizione
Set di 10 piastre di Petri pre-colate con agar, pronte per esperimenti scientifici! Diametro 7 cm, spessore uniforme per una crescita ottimale di colture. Materiale di alta qualità, sicuro e facile da usare. Perfette per scuole, hobby o progetti STEM. Risparmia tempo evitando di preparare l'agar. Ispira curiosità e apprendimento!Caratteristiche e scheda tecnica
Caratteristiche principali
- EAN3682261766665
Recensioni
2026-02-18 | 48lllld